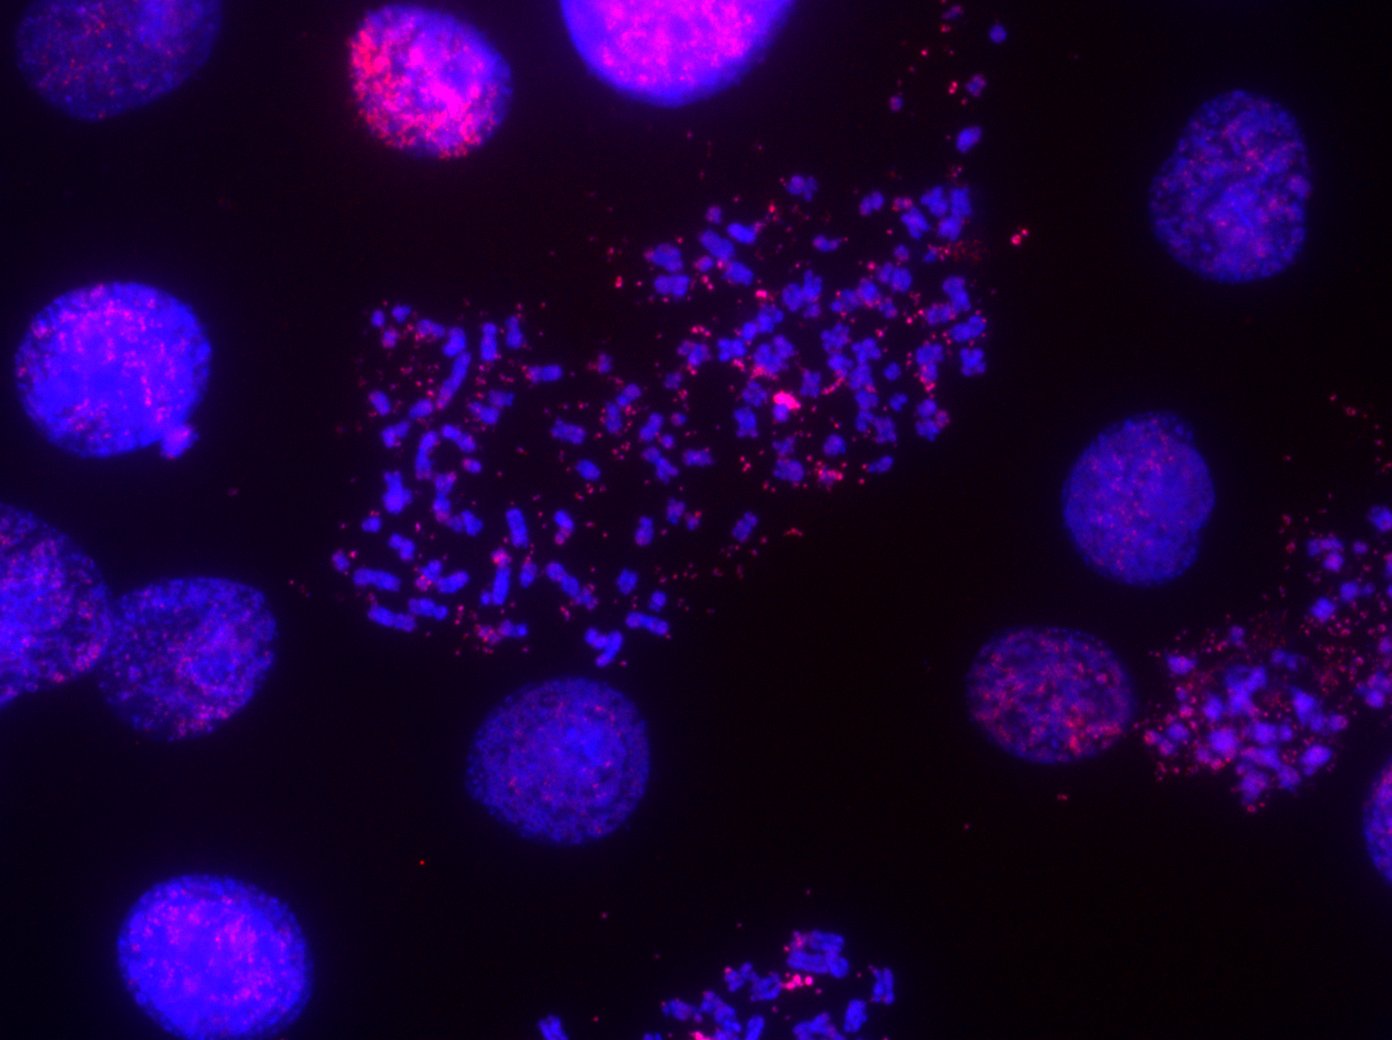

Decoding how genetic variation reshapes cellular systems and drives adaptation.
Our lab investigates how genetic variation reshapes cellular systems, from protein mutations to large-scale genome alterations. We integrate computational biology, interpretable machine learning, and multiomic data to uncover how molecular changes propagate through regulatory networks and genome architecture to influence cellular phenotypes and evolutionary dynamics.
Interpreting Genetic Variation at Scale
Understanding how genetic variants alter molecular function remains one of the central challenges in biology and medicine. Our lab develops interpretable AI frameworks that integrate protein structure, population-scale multiomics data, and regulatory network models to identify regions of functional importance within proteins and predict how mutations reshape transcriptional and signaling networks. By linking molecular variation to systems-level consequences, this work aims to improve variant interpretation and uncover new regulatory mechanisms relevant to disease.





Evolutionary Dynamics of ecDNA
Cells can rapidly evolve through structural changes to the genome that generate extreme genetic heterogeneity. Our lab studies how extrachromosomal DNA (ecDNA) and other structural DNA variants reshape genome architecture, alter gene regulation, and influence cellular fitness. Using single-cell genomics, quantitative imaging, and computational modeling, we investigate how ecDNA copy number variation drives phenotypic diversity and enables rapid adaptation in changing environments.

You must be logged in to post a comment.